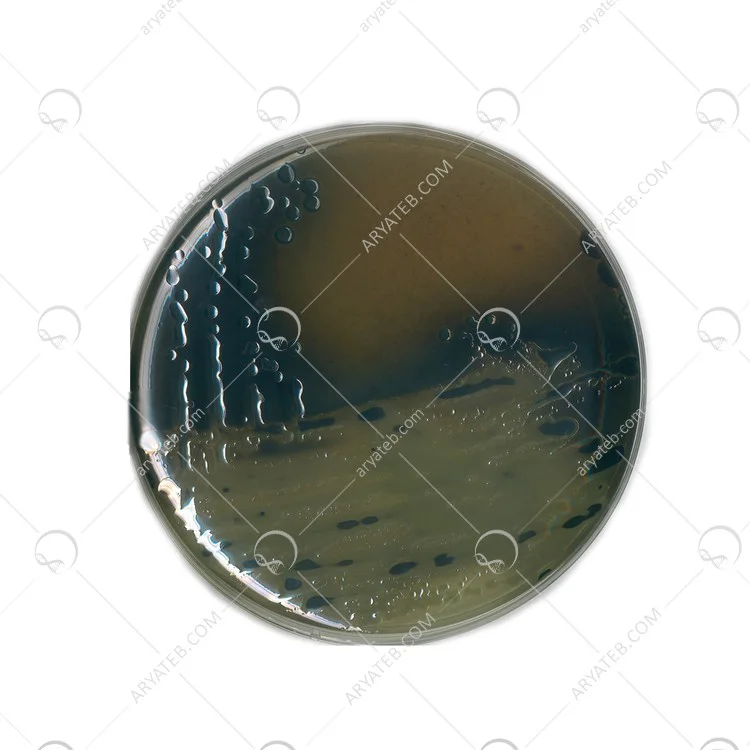

محیط کشت بیسموت سولفیت آگار
تماس بگیرید
به علت نوسانات قیمت امکان ثبت سفارش به صورت آنلاین مقدور نمی باشد ، لطفا تماس حاصل فرمایید .
تماس بگیرید
قیمت ویژه همکاران
اکانت شما ویژه همکاران نمی باشد
محیط کشت bismuth sulfite agar
سالمونلا پیچیده ترین گروه باکتری در بین انتروباکتریاسه ها است. عفونت سالمونلا در انسان معمولاً در اثر مصرف غذا، آب یا شیر آلوده به مدفوع انسان یا حیوان ایجاد می شود. انسان ها تنها مخزن S. Typhi هستند. مهم است بدانید که چهار نوع بالینی عفونت سالمونلا قابل تشخیص است: التهاب گوارشی، باکتریمی یا سپسیس، تب روده و ناقلین.
محیط های مختلفی برای جداسازی و شناسایی سالمونلا استفاده می شود که شایع ترین آنها سالمونلا تیفی است.
.jpg)
اجزای تشکیل دهنده محیط کشت BSA
.jpg)
محیط کشت BSA
طرز تهیه محیط کشت Bismuth Sulphite Agar
- 52.33 گرم از محیط BSA را در 1000 میلی لیتر آب مقطر معلق کنید.
- محلول را تا انحلال کامل محیط گرم کنید.
- با اتوکلاو یا استریل کردن استریل نکنید، زیرا گرمای بیش از حد ممکن است انتخاب محیط را به خطر بیندازد.
- خوب مخلوط کنید تا سوسپانسیون پخش شود و در صفحات ضخیم (25 میلی لیتر محیط در هر بشقاب) بریزید. اجازه دهید محیط زمانی که در درب آن نیست جامد شود.
- قبل از استفاده صفحات را خشک کنید، اما مراقب باشید که آنها را بیش از حد خشک نکنید.
- برگ هایی که به درستی آماده شده اند باید کرمی و صاف با رنگ نی روشن باشند. عجله نکن
- باید علامتی وجود داشته باشد.
- صفحات را با نمونه بکارید.
- تلقیح را به مدت 48 ساعت در دمای 35 درجه سانتیگراد و پس از 24 ساعت برای کلنی های معمولی انکوبه کنید. اگر بعد
- از 48 ساعت، صفحات رشد کمی دارند یا اصلا رشد نمی کنند، 24-28 ساعت دیگر انکوبه کنید.
برای دیدن انواع محیط کشت کلیک کنید
نظر خود را ارسال کنید
آدرس ایمیل شما منتشر نخواهد شد. فیلدهای الزامی علامت گذاری شده اند *
قیمت ویژه همکاران
اکانت شما ویژه همکاران نمی باشد
اطلاع از موجودی